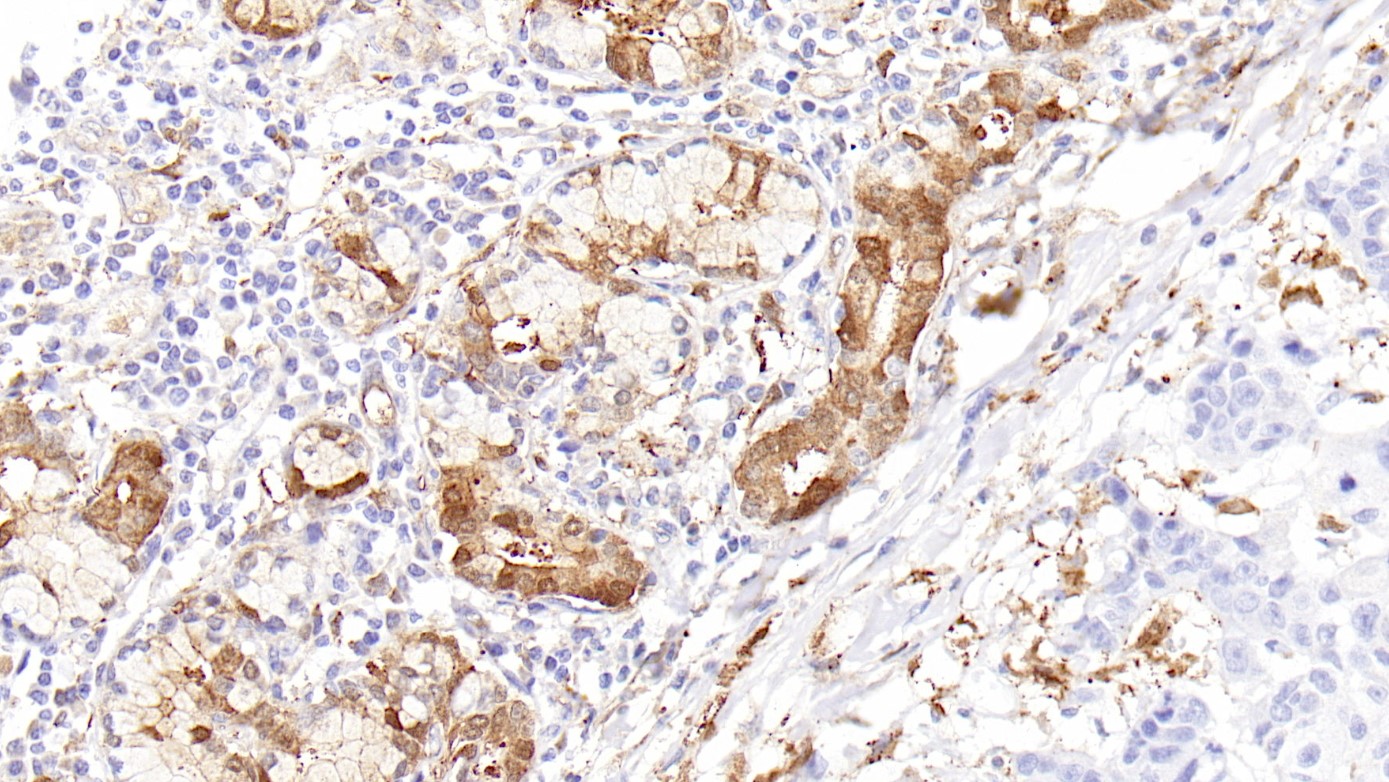

1.Expression of calretinin in odontogenic keratocysts and basal cell carcinomas: A study of sporadic and Gorlin-Goltz syndrome-related cases[J]. Anna Maria Cesinaro,Giammarco Burtini,Antonino Maiorana,Giulio Rossi,Mario Migaldi. Annals of Diagnostic Pathology.
2.Serum calretinin as an independent predictor for platinum resistance and prognosis in ovarian cancer.[J]. Link Theresa,Passek Simon,Wimberger Pauline,Frank Kerstin,Vassileva Yana Damyanova,Kramer Michael,Kuhlmann Jan Dominik. International journal of cancer. 2020(9)
3.中华医学会.《临床技术操作规范·病理学分册》.人民军医出版社,2004.